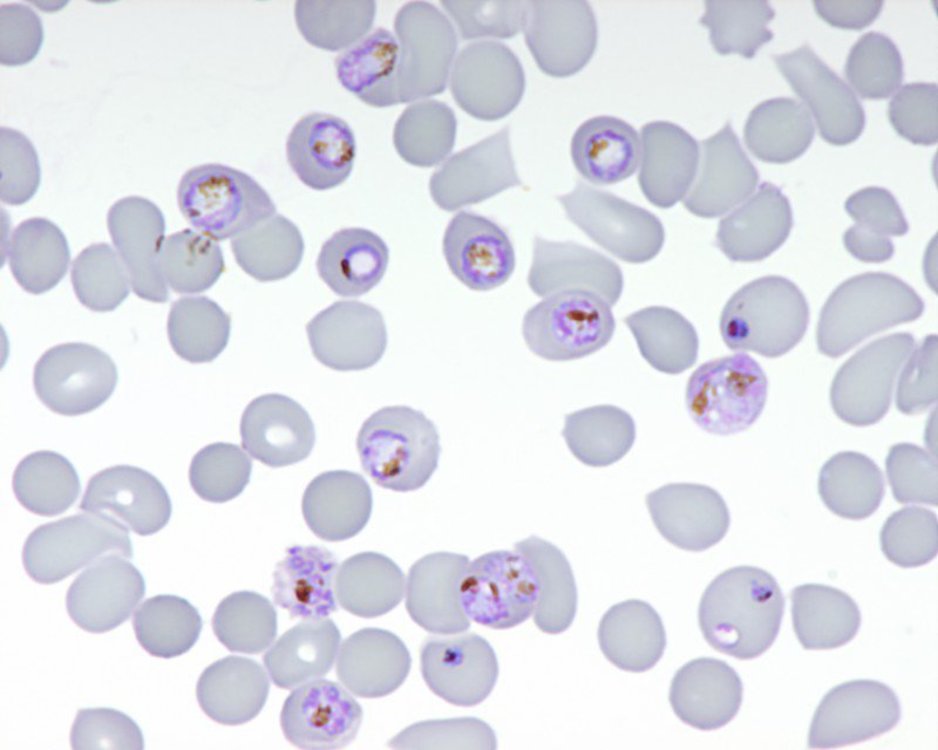

20 mg de sciences in situ : Soigner le paludisme
Publié par Morgane Bouterre, le 23 juillet 2018 3.9k
Première diffusion le dimanche 22 février 2015, campusfm (Toulouse, 94 MHz). Image d'illustration : Globules rouges infectés par différents stades parasitaires de Plasmodium falciparum.
Françoise Benoit-Vical dirige l’équipe de recherche « Nouvelles molécules antipaludiques et approches pharmacologiques » au laboratoire de Chimie de Coordination du CNRS, à Toulouse. Il s’agit d’une équipe multidisciplinaire comprenant des biologistes, des chimistes, des pharmaciens et des cliniciens, travaillant sur de nouvelles approches thérapeutiques pour le traitement du paludisme et de la leishmaniose.
Dans le cas du paludisme, maladie responsable de près de 1 million de morts chaque année, les travaux de recherches de cette équipe sont orientés selon 3 axes :
– l’identification des principes actifs présents dans les plantes utilisées en médecine traditionnelle et la recherche de nouveaux principes actifs issus de synthèses chimiques
– la compréhension des mécanismes d’action de ces principes actifs
– la compréhension des mécanismes de résistance de Plasmodium falciparum, le parasite responsable de la maladie.
Interview : Cédric Olivier Turrin / Mise en onde : Thomas Delafosse
Plus d'infos :
Sur les travaux de Françoise Benoit-Vical :
- http://www.inserm.fr/espace-journalistes/comment-le-parasite-responsable-des-formes-graves-de-paludisme-resiste-a-un-antipaludique-majeur http://www.lcc-toulouse.fr/lcc/spip.php?article1072
- http://www2.cnrs.fr/presse/communique/3367.htm?debut=24&theme1=5
- http://www2.cnrs.fr/presse/communique/3847.htm